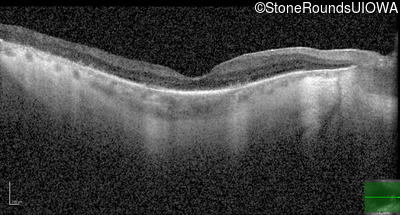
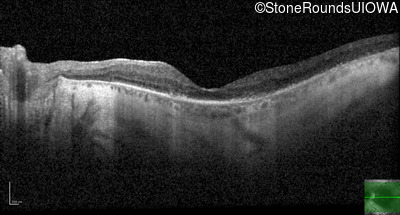

Case
SR4274
Student Mode
AR Retinitis Pigmentosa (IA1aiii)
Male
Male
Hidden
SR4274
Student Mode
AR Retinitis Pigmentosa (IA1aiii)
Male
Male
History
This 71 year old man first noticed difficulties seeing in dim light at age 20. He was in the military and recalls needing a flashlight that other service men did not.
Diagnosis & molecular findings
| Disease | Gene | Allele 1 variant(s) | Allele 2 variant(s) | Inheritance mode |
|---|---|---|---|---|
| AR Retinitis Pigmentosa | USH2A | Gly2224Cys GGT>TGT / Glu3448Lys GAA>AAA | IVS45-2 A>G | AR |
Disease:
Gene:
Allele 1:
Gly2224Cys GGT>TGT / Glu3448Lys GAA>AAA
Allele 2:
IVS45-2 A>G
Inheritance:
AR